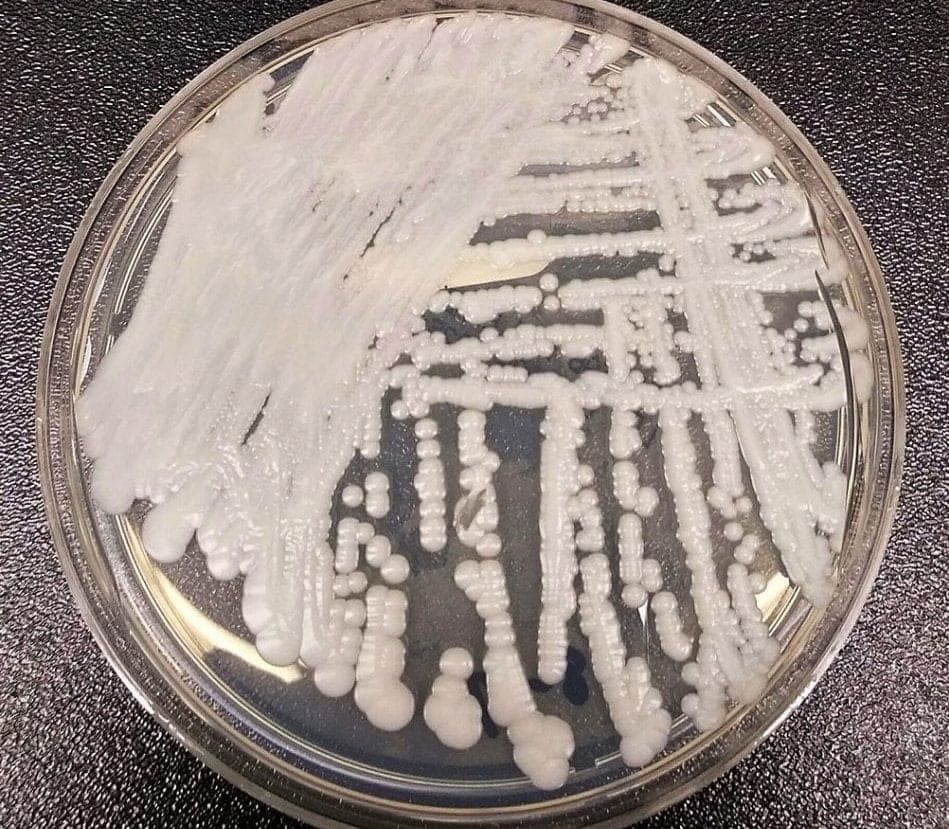
Reportan en Brasil posible caso de infección por 'Candida auris', un hongo peligroso

Reportan en Brasil posible caso de infección por 'Candida auris', un hongo peligroso
R
Ricardo Zapata·
Brasil.- Se han encendido las alarmas en el país sudamericano con el posible primer caso positivo por la "Candida auris", un hongo que se resiste a los principales medicamentos antifúngicos.
Esta infección fue detectada el pasado 7 de diciembre en un paciente que ingresó a una unidad de cuidados intensivos en un hospital del estado de Bahía, por el momento se hacen análisis para confirmar el diagnóstico.
Para poder prevenir la propagación del virus, se ha conformado un grupo multidisciplinario para poder hacer frente a esta situación, ya que el hongo ingresa al torrente sanguíneo y puede diseminarse por todo el cuerpo.
Una vez que el hongo está en el cuerpo, lleva a producir infecciones graves que pueden producir hasta 40% de mortalidad hospitalaria, en algunos países como EU se han detectado brotes.
Con información de RT


